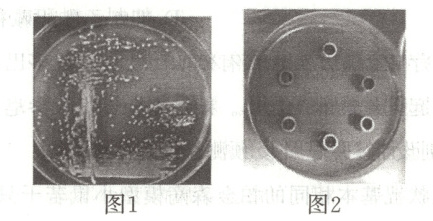

2026年薪火金卷高考仿真模拟卷生物
注:目前有些书本章节名称可能整理的还不是很完善,但都是按照顺序排列的,请同学们按照顺序仔细查找。练习册 2026年薪火金卷高考仿真模拟卷生物 答案主要是用来给同学们做完题方便对答案用的,请勿直接抄袭。
第5页
- 第1页
- 第2页
- 第3页
- 第4页
- 第5页
- 第6页
- 第7页
- 第8页
- 第9页
- 第10页
- 第11页
- 第12页
- 第13页
- 第14页
- 第15页
- 第16页
- 第17页
- 第18页
- 第19页
- 第20页
- 第21页
- 第22页
- 第23页
- 第24页
- 第25页
- 第26页
- 第27页
- 第28页
- 第29页
- 第30页
- 第31页
- 第32页
- 第33页
- 第34页
- 第35页
- 第36页
- 第37页
- 第38页
- 第39页
- 第40页
- 第41页
- 第42页
- 第43页
- 第44页
- 第45页
- 第46页
- 第47页
- 第48页
- 第49页
- 第50页
- 第51页
- 第52页
- 第53页
- 第54页
- 第55页
- 第56页
- 第57页
- 第58页
- 第59页
- 第60页
- 第61页
- 第62页
- 第63页
- 第64页
- 第65页
- 第66页
- 第67页
- 第68页
- 第69页
- 第70页
- 第71页
- 第72页
- 第73页
- 第74页
- 第75页
- 第76页
- 第77页
- 第78页
- 第79页
- 第80页
- 第81页
- 第82页
- 第83页
- 第84页
- 第85页
- 第86页
- 第87页
- 第88页
- 第89页
- 第90页
- 第91页
- 第92页
- 第93页
- 第94页
- 第95页
- 第96页
12. 松墨天牛是危害松属植物的主要害虫,也是有松树“癌症”之称的松材线虫病的主要传播媒介昆虫。该虫 1 年发生 1 代,春季新羽化的成虫取食嫩松枝补充营养,7 月中旬至 8 月上旬成虫交配产卵,冬季则以老熟幼虫在木质部中越冬。科研人员研究了不同树种组成对松墨天牛成虫种群数量的影响,结果如下图所示。下列说法正确的是(

A.松墨天牛与松树、松材线虫与松树间的关系均为寄生
B.松墨天牛成虫的林间防治期以 7 月中旬至 8 月上旬最佳
C.8 月下旬松墨天牛数量急剧减少的原因是种内斗争加剧
D.与纯林相比,混交林对松墨天牛的抵抗力更高
D
)
A.松墨天牛与松树、松材线虫与松树间的关系均为寄生
B.松墨天牛成虫的林间防治期以 7 月中旬至 8 月上旬最佳
C.8 月下旬松墨天牛数量急剧减少的原因是种内斗争加剧
D.与纯林相比,混交林对松墨天牛的抵抗力更高
答案:
D [由题干信息可知,松墨天牛是有松树“癌症”之称的松树线虫病的主要传播媒介昆虫,春季新羽化的成虫取食嫩松枝补充营养,7月中旬至8月上旬成虫交配产卵,冬季则以老熟幼虫在木质部中越冬,所以松墨天牛与松树的种间关系是捕食和寄生,松树线虫与松树间的关系为寄生,A错误;由题干信息可知,松墨天牛在7月中旬至8月上旬成虫交配产卵,使得种群数量增加,所以对松墨天牛成虫的林间防治期以7月中旬以前最佳,B错误;由题干信息可知,松墨天牛属于一年生昆虫,所以在7月中旬至8月上旬成虫交配产卵后衰老死亡,使得8月下旬松墨天牛数量急剧减少,C错误;由图中信息可知,与纯林相比,混交林中松墨天牛的数量相对更低,说明混交林对松墨天牛的抵抗力更高,D正确。故选D。]
13. 细菌素是某些细菌产生的具有抑菌活性的多肽类物质,可代替食品防腐剂使用,且安全性较高。研究者已证明乳酸菌代谢过程中分泌的细菌素可抑制金黄色葡萄球菌。牛津杯是一种钢制的空心小管,将其插在琼脂培养基上时,加入杯中的液体可以逐渐渗透到培养基中,利用该装置可进行细菌素抑菌实验。下列关于该实验的叙述不正确的是(

A.图 1 的接种方法为平板划线法
B.图 2 进行抑菌实验时,平板中接种乳酸菌,牛津杯中加入金黄色葡萄球菌的培养液
C.细菌素代替食品防腐剂且安全性较高的原因之一,在于细菌素可被消化液中的酶分解
D.为获得具有高效抗菌活性的乳酸菌菌种,可以从酸奶和泡菜中筛选乳酸菌进行培养
B
)
A.图 1 的接种方法为平板划线法
B.图 2 进行抑菌实验时,平板中接种乳酸菌,牛津杯中加入金黄色葡萄球菌的培养液
C.细菌素代替食品防腐剂且安全性较高的原因之一,在于细菌素可被消化液中的酶分解
D.为获得具有高效抗菌活性的乳酸菌菌种,可以从酸奶和泡菜中筛选乳酸菌进行培养
答案:
B [图1中菌落在平板中分布不均匀,可判断接种方法为平板划线法,A正确;图2是验证细菌素可抑制金黄色葡萄球菌,故平板中需要接种金黄色葡萄球菌,牛津杯中加入细菌素,根据抑菌圈的大小可判断细菌素的抑制作用,B错误;细菌素作为一种多肽类,进入人体肠道可以被消化酶分解,安全性较高,C正确;酸奶和泡菜的主要发酵菌种是乳酸菌,故可以从其中获得乳酸菌,D正确。故选B。]
查看更多完整答案,请扫码查看


